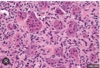

Primary HyperPTH diagnostic test?
ELEVATED PTH and Calcium
Remember, asymptomatic hypercalcemia and Nephrolithiasis
The most common clinical presentation of primary hyperparathyroidism (PHPT) is asymptomatic hypercalcemia. The diagnosis is usually first suspected because of the incidental finding of an elevated serum calcium concentration on biochemical screening tests. In addition, PHPT may be suspected in a patient with nephrolithiasis.
If hypercalcemia is confirmed, intact parathyroid hormone (PTH) should be measured concomitantly with the serum calcium. PHPT is diagnosed by finding a frankly elevated PTH concentration in a patient with hypercalcemia. When the PTH is only minimally elevated or within the normal range (but inappropriately normal given the patient’s hypercalcemia), PHPT remains the most likely diagnosis, although familial hypocalciuric hypercalcemia (FHH), a rare disorder, is possible (Uptodate)
PTH serum levels is the answer
Primary hyperPTH phosphate?
= low phosphate
What is the most common cause of secondary hyperparathyroidism?
Chronic Kidney disease?
In primary hyperparathyroidism, what is the calcium, phosphate & all phos labs look like
Primary Hyperparathyroidism-Calcium is high and phosphate is low
Calcium and Phosphate always go in opposite directions, if one if high the other is low, because if both are higher they can crystalize in the blood so body prevents this at all costs.
In secondary hyperparathyroidism, what is the calcium, phosphate & all phos labs look like
Secondary Hyperparathyroidism-Calcium is low and phosphate is high. All phosphate is normal
Calcium and Phosphate always go in opposite directions, if one if high the other is low, because if both are higher they can crystalize in the blood so body prevents this at all costs.
In paraneoplastic hyperparathyroidism, what is the calcium, phosphate & all phos labs look like
Paraneoplastic Hyperparathyroidism-Calcium is high and phosphate is low. Alk phosphate is norm
Calcium and Phosphate always go in opposite directions, if one if high the other is low, because if both are higher they can crystalize in the blood so body prevents this at all costs.
Describe calcium phosphate, and all phos levels in…
Paget’s Disease
Cherubsim
Fibrous Dysplasia
Ossifying firm
Calcium and Phosphate always go in opposite directions, if one if high the other is low, because if both are higher they can crystalize in the blood so body prevents this at all costs.

- Obstructive and restrictive lung disease similarity?
SAME TIDAL VOLUME
= reduced FEV1, unchanged TV, SOB with exertion and

What is the difference between Obstructive and Restrictive/obesity lung volumes
Obstructive = decreased FEV1/FVC. Increased residual volume, functional residual capacity, and (?) tidal volume. Restrictive/Obesity = normal to increased FEV1/FVC ratio. Decreased TLC, RFC, and RV.
Difference between obstruction and restrictive lung diseases
Looks like total lung capacity in obstructive lung disease is higher.

- What is Protein C?
STRONG PHYSIOLOGIC ANTICOAGULANT
Serine protease; Autoprothrombin IIa and blood coagulation factor XIV. Inactivates factor Va and VIIIa in anticoagulation.
Protein C is produced in the liver, and is Vit K dependant, and part of the regulation of the clotting cascade, it is activated when coming into contact with active thrombin in the blood. Test answer potent anticoagulant
- First degree block treatment?
PACEMAKER
= Asymptomatic patients with first degree AV block do not require any specific therapy.
= The rare patient with first degree AV block and symptoms consistent with the loss of atrioventricular synchrony, a situation sometimes referred to as “pacemaker syndrome,” is a potential candidate for a pacemaker. Other
situations in which a pacemaker may be considered for first degree AV block include patients with concurrent neuromuscular disease and patients with a wide QRS complex with suspected conduction delay below the AV node.
First degree is increased PR interval of over .2 seconds
- Reversible asthma FEV? = answer 12% and 200mL
= Reversibility is present if there is at least a 12% and 200mL increase in the FEV1 after bronchodilator given.
Multiple sclerosis = answer was 3 key words
Auto immune central demyelination

- Serotonin syndrome treatment?
Cyproheptadine H1 antagonist (antihistamine)
At high concentrations, has antiserotonergic (5HT2 – excellent for tx of SS), anticholinergic, antidopaminergic effects.
Symptoms of Serotonin Syndrome:
tremors, myoclonus, hyperreflexia, mydriasis, GI symptoms (N/V/D).
Five principles are central to the management of serotonin syndrome:
- Discontinuation of all serotonergic agents
- Supportive care aimed at normalization of vital signs
- Sedation with benzodiazepines
- Administration of serotonin antagonists
- Assessment of the need to resume use of causative serotonergic agents after resolution of symptoms
Which drug may induce Serotonin syndrome when combined with a selective serotonin reuptake inhibitor.
Alafentanil
Fentanyl
Meperiidine
Morphine
Meperidine
Serotonin syndrome is characterized by confusion agitation tachycardia, fever, hyperreflexia, mydriasis, myoclonus. Normeperidine is an active metabolite of meperidine
- Transfusion related complication?
Transfusion-related acute lung injury (TRALI) = uncommon syndrome due to the presence of leukocyte antibodies in transfused plasma. TRALI is believed to occur in approximately one in every 5000 transfusions.
Leukoagglutination and pooling of granulocytes in the lungs may occur, with release of the contents of leukocyte granules, and resulting injury to cellular membranes, endothelial surfaces, and potentially to lung parenchyma. Management of the patient with TRALI includes immediate discontinuation of the transfusion and reporting to the blood bank that TRALI is suspected. Therapy is supportive with supplemental oxygen and ventilatory support with lung protective strategies when clinically indicated. Although the risk for mortality is significant, patients who survive a TRALI episode are generally expected to recover completely.
- Phenytoin and Tylenol toxicity
Answer was something to do with enzyme or slowing processing
Found some articles discussing this and phenytoin increases the liver toxicity of Tylenol.
Phenytoin induces the p450 enzymes CYP3A4 and CYP2C but not CYP2E1 or CYP1A2. Like carbamazepine, the
induction of CYP3A4 by phenytoin may lead to increased production of NAPQI from APAP.
- EKG of WPW (Wolf-Parkinson-White
A delta wave is slurring of the upstroke of the QRS complex b/c the action potential from the sinoatrial node is able to conduct to the ventricles very quickly through the accessory pathway, and thus the QRS occurs immediately after the P wave, making the delta wave.
The combination of WPW and atrial fibrillation can potentially be fatal, especially if AV blocking agents are given (remember “ABCD” for adenosine, amiodarone, beta-blockers, calcium channel blockers and digoxin).
The medical treatment = procainamide (sodium channel blocker, Class I-A antiarrhythmic drug).

Which medication should you not use in WPW
DO NOT USE adenosine in WPW. It has been proven to cause VFIB. By blocking the AV node the extra electric pathway can go nuts. Also, the delta wave slurring can be on the front or back part of the QRS complex. Talked with multiple people, including anesthesiologists about this.
Wolff-Parkinson-White
What is it, what symptoms, and what treatment.
A syndrome in which an extra electrical pathway in the heart causes a rapid heartbeat.
The extra electrical pathway in Wolff-Parkinson-White syndrome appears between the heart’s upper and lower chambers and is present at birth.
Symptoms most often appear between the ages of 11 and 50 and include a rapid pounding heartbeat, dizziness, and lightheadedness.
Treatment may involve the use of medications or a procedure known as ablation. In rare instances, an electric shock may be used to restore a normal rhythm.

Wolfe Parkinson White Syndrome